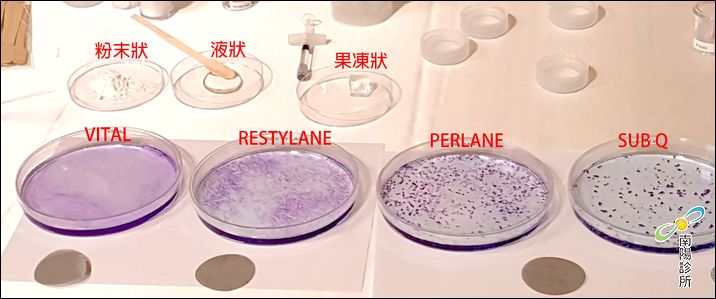

最新消息
【美容醫學饗宴】2016年Restylane玻尿酸20周年紀念高峰會
2016年6月19日,Restylane玻尿酸20周年紀念慶典,於台北萬豪酒店隆重盛大展開!
擁有世界最大廠——Restylane玻尿酸多年注射經驗的大師級醫師們,
一同受邀參與盛典,並在台上展開精闢又生動的大師級對談。

鄧守成院長亦受邀參與此次高峰會,與其他大師級醫師們一同談論玻尿酸注射微整的經驗。
當天,瑞典Restylane NO.1員工——玻尿酸注射劑創始人Per先生,
也親臨現場,一同紀念這個重要時刻,
分享「瑞絲朗玻尿酸」截至目前已累積高達2800萬注射人次的殊榮!

難得的是,當天會場完整展覽了原廠玻尿酸製劑的原料
半成品的各種型態、不同大小分子的玻尿酸,都一覽無遺

雖身為大師級醫師受邀參與,鄧守成醫師依然細膩觀察玻尿酸原料不同形式之展示品
用手一一觸摸,親自體驗各種質地的差異

↑大分子的玻尿酸劑型,呈現透明凝露、果凍狀,如上圖所示

↑細小分子的玻尿酸,則為清澈透明液狀,如上圖所示
活動中也不斷有媒體邀請訪問,眾人都對鄧醫師在玻尿酸注射領域裡那歷久彌新的技術感到很有興趣,也相當敬佩。
鄧醫師相當有大師的風範跟氣質呢!

(身為南陽診所護理師,放上鄧醫師的帥照,當然是我的職責囉!)
投入醫學美容領域的大師級醫師們,
多年來致力於「使人更美」、「看不出真實年齡」等追求,
不僅要身兼數職,除了當醫師以外,
舉凡醫學院老師、受邀擔任醫學會講師、
與醫療同業、醫院同事、醫界同仁們進行專業的學術交流、
擔任客人的專業美學諮詢顧問、不斷累積微整形與整形手術之各種美學經驗,
指導並提攜後輩、甚至帶領其他醫師與護理師共同增廣見聞、
使他們成為自己最得力的助手,一同參與愛美朋友的美麗旅程......

這些,缺一不可,都是必要的經歷,條條都是通往「大師級醫師」的必經之路。
鄧守成醫師這一路走來,隨著經驗逐漸累積,
以追求整形外科醫美學問的心血,層層堆疊於專業基礎之上,
熱忱絲毫不減,帶著一顆天天年輕開朗的赤子之心,
才能妙手回春,讓愛美的朋友們也在其仁心仁術之下,
找回青春亮麗的自己!

